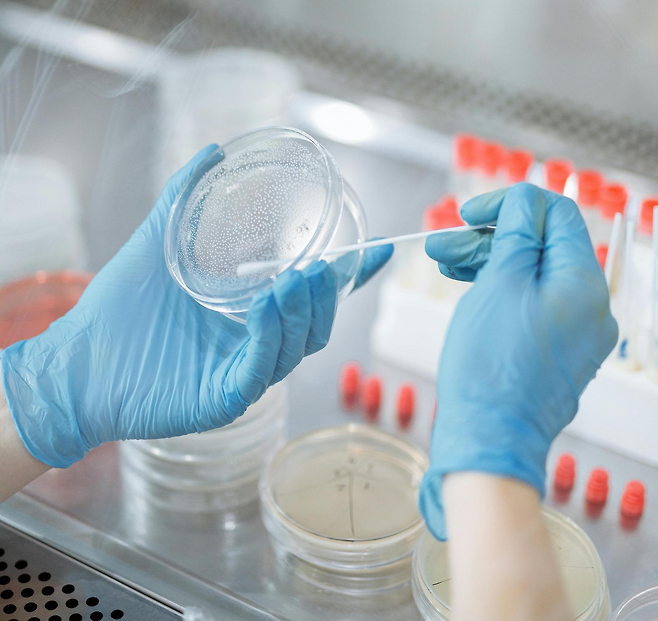

“유산균 먹기 시작했는데 오히려 배가 더 더부룩해요.”
“가스가 차고, 배가 빵빵해진 느낌이 들어요.”
“변비가 좋아지긴커녕 속이 불편해졌어요.”
의외로 이런 경험을 하는 사람이 많습니다. 그리고 이건 유산균이 안 맞아서라기보다,먹는 방식이나 장 상태가 맞지 않아서 생기는 경우가 대부분입니다.
유산균에 대한 흔한 오해

❌ “유산균은 많이 먹을수록 좋다”
❌ “아무 때나 먹어도 된다”
❌ “더부룩한 건 처음이라서 그렇다”
유산균은 ‘살아 있는 미생물’입니다. 즉, 내 장 환경에 들어와 정착하거나 경쟁을 해야 합니다.
그래서 장 상태에 따라 도움이 될 수도 오히려 불편함을 키울 수도 있습니다.
유산균 먹고 더 더부룩해지는 진짜 이유

✔ 장 내 가스 생성이 늘어났을 때
유산균은 장에서 발효 작용을 합니다. 이 과정에서 가스가 생기는데, 이미 장 운동이 느리거나 가스 배출이 잘 안 되는 사람은 이 가스가 빠져나가지 못해 더부룩함을 느끼게 됩니다.
특히 이런 경우에 흔합니다.
- 평소 배에 가스가 잘 차는 사람
- 변비가 오래된 사람
- 배가 단단하게 빵빵해지는 타입
✔ SIBO(소장 세균 과다 증식) 가능성
유산균을 먹고 복부 팽만이 심해지고 트림, 방귀가 늘고, 식후 바로 배가 불러온다면 소장에 이미 세균이 많은 상태일 수 있습니다.
이때 유산균을 추가로 넣으면 장이 더 혼잡해지고 불편감이 심해질 수 있습니다.
공복 섭취가 오히려 독이 되는 사람들
“유산균은 공복에 먹어야 좋다”는 말, 많이 들어보셨죠. 하지만 모든 사람에게 맞는 원칙은 아닙니다.
공복에 먹으면 위산 자극과 장 운동 저하, 속 쓰림, 더부룩함이 생기는 사람이 있습니다.
특히
- 위장이 약한 사람
- 아침에 속이 예민한 사람
- 공복에 가스 잘 차는 사람은
식후 섭취가 더 편할 수 있습니다.
그럼 유산균, 어떻게 먹어야 할까?
✔ 한 가지 제품만
→ 여러 균을 동시에 먹지 않기
✔ 식후 섭취부터 시도
→ 공복이 꼭 정답은 아님
✔ 용량 줄여서 시작
→ 반 캡슐, 격일 섭취도 충분
✔ 더부룩하면 잠시 중단
→ 억지로 계속 먹지 않기
유산균은 ‘참아서 먹는 보충제’가 아닙니다. 몸이 불편하다는 신호를 보내면, 그 신호를 존중해야 합니다.
유산균은 장 상태가 준비됐을 때 효과를 냅니다.
장 운동, 수분 섭취, 식사 리듬이 먼저 잡히지 않으면 아무리 좋은 유산균도 “장에 좋은 일”을 하기가 어렵습니다.
더부룩해졌다는 건 유산균이 나쁘다는 뜻이 아니라, 지금 내 장이 먼저 돌봄을 필요로 한다는 신호일 수 있습니다.
Copyright © 해당 콘텐츠의 저작권은 3분건강레터에게 있습니다.